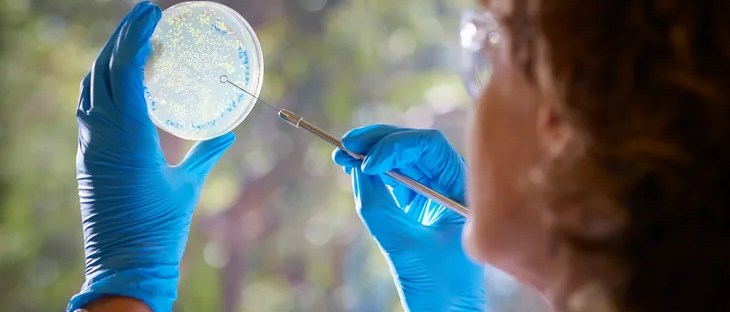

Meet the synthetic biology startup on the frontlines of a deep tech revolution, producing sustainable and carbon-negative hydrogen fuel from renewable agricultural waste biomass.
Read the full story here.
Meet the synthetic biology startup on the frontlines of a deep tech revolution, producing sustainable and carbon-negative hydrogen fuel from renewable agricultural waste biomass.
Read the full story here.